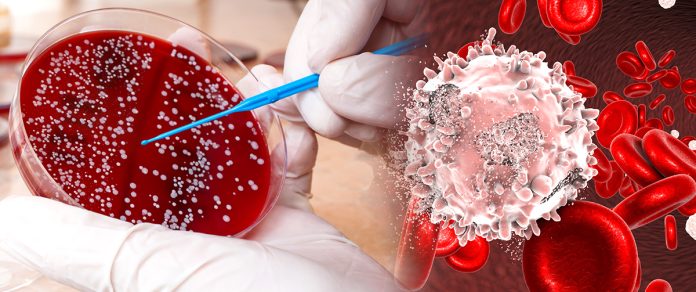

ලෝකය පුරා බොහෝ දෙනෙක් බිළිගත් මාරකයක් තමයි පිළිකා රෝගය. අපේ සිරුරේ විවිධ තැන් වල විවිධ පිළිකා වර්ග හටගන්නවා. ඒ අතර එක් පිළිකාවක් තමයි රුධිරයේ ඇති වන පිළිකා සමහරු එය ලේ පිළිකා ලෙසයි හඳුන්වන්නේ. මේ රුධිරයේ හැදෙන පිළිකා ප්රධාන වශයෙන් වර්ග 3ක් තියෙනවා.
ලියුකේමියා
මෙය ප්රධානතම ලේ පිළිකා වර්ගයක්. මේකෙත් වර්ග කිහිපයක්ම තියෙනවා. ප්රධාන වශයෙන් ඇකියුට් ලියුකේමියා හා ක්රොනික් ලියුකේමියා ලෙස වර්ග දෙකකට බෙදෙනවා.ඒ වගේම රතු රුධිරාණු, සුදු රුධිරාණු හා රුධිර පට්ටිකා වැඩිවන හා අඩුවන විවිධ ලියුකේමියා වර්ගත් පවතිනවා.
සාමාන්ය රුධිර පරීක්ෂාවකින් මෙම ලියුකේමියා තත්වය හඳුනාගන්න පුළුවන්. ඒ වගේම උණ රෝගී තත්වයන් පරික්ෂා කිරීමේදී සහ බෝන් මැරෝ පරීක්ෂාවෙන් ද ලියුකේමියාව හඳුනාගැනීමේ හැකියාව පවතිනවා. සමහර ලියුකේමියා වර්ග කිසිම රෝග ලක්ෂණයක් නොපෙන්වා දීර්ඝ කාලයක් පවතින්නත් පුළුවන්.
රෝග ලක්ෂණ
අධික මහන්සිය
අසාමාන්ය ලෙස ලේ ගැලීම
උණ
විදුරුමස්වලින් ලේ යෑම
මාසික ඔසප්වීමේදී අධික ලෙස රුධිරය පිටවීම
සම යටින් ලේ ගැලීම (රතු පැල්ලම් ලෙස පෙනේ)
ලිම්ෆෝමා
මෙම පිළිකා තත්වය ඇති වන්නේ වසා පද්ධතියේයි. සමහර වෛරස නිසා ලිම්ෆෝමා වර්ගයේ රැධිර පිළිකා හැදෙන්න පුළුවන්. ලේ පරීක්ෂාව, වසා ගැටිති පරීක්ෂාව හෝ බෝන් මැරෝ පරීක්ෂාවෙන් එය හඳුනාගත හැකියි.
රෝග ලක්ෂණ
වසා ගැටිති (කුද්දැටි) ඉදිමී
ශරීරයේ බර අඩුවීම
අධික ලෙස දහඩිය දැමීම
කැස්ස
හුස්ම හිරවීම
කැසීම
මයලෝමා
මයලෝමා කියන්නේ ප්ලාස්මා සෛලවල (බෝන් මැරෝ ආශ්රිත) සෑදෙන පිළිකා වර්ගයක්. Multiple Myeloma ලෙස හැඳින්වෙන තත්ත්වයේ දී ප්ලාස්මා සෛල ලෙස හැඳින්වෙන සුදු රුධිරාණු බහුල වී ඒවායින් ශරීර අවයවවලට හානිකර ද්රව්ය නිකුත් කරනවා. එක්ස්රේ පරීක්ෂාව, රුධිර පරීක්ෂාව හෝ බෝන් මැරෝ පරීක්ෂාව මගින් මෙම රෝගී තත්වය හඳුනාගන්න පුළුවන්.
රෝග ලක්ෂණ
කොන්දේ කැක්කුම
වකුගඩු නරක්වීම
අධික මහන්සිය
බර අඩුවීම
නිතර ආසාදන තත්වයන්
කකුල් වල දුර්වලතා
අධික පිපාසය
ආහාර අරුචිය
ඔක්කාරය
පපුවේ සහ අස්ථි වේදනාව
සාමාන්යයෙන් විකිරණවලට නිරාවරණය වීම, රසකාරක දැමූ ආහාර ගැනීම වැනි විවිධ හේතු පිළිකා ඇති වෙන්න බලපානවා. සමහර වෙලාවට පරම්පරාවෙන් රෝගයක් ලෙස වැළඳෙන පිළිකා වර්ගත් තියෙනවා. හැබැයි රුධිර පිළිකා හැදෙන ආකාරය නම් තවමත් සොයාගෙන නැහැ. හැබැයි නිවැරදිව ප්රතිකාර කිරීමෙන් රුධිර පිළිකා සුව කරගත හැකියි.
(behappy වෙඩ් අඩවිය)